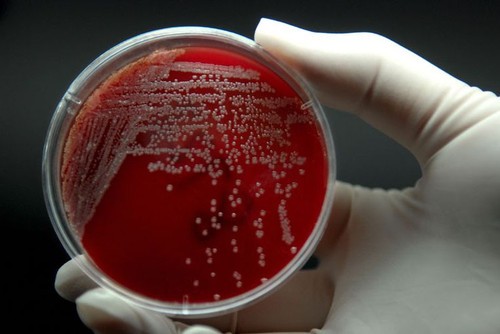
���ಡ����40%  �յ���Ⱦ�ж����

1PM2.5颗粒物对人类健康危害
2014年3月份,世界卫生组织发布的一个含有最新的数据研究报告指出空气污染目前是我们人类健康的杀手,是无声杀手。3月25号,WHO发布了公告指出,截止到2012年空气污染造成非正常死亡人数,过早的死亡,跟空气污染有关系的这种非正常死亡达到了700万人。据较保守的调查,每八位死者中有一位死于跟空气污染有关。这个数据跟我们粗略估计要高两倍多。
一个空气污染是世界上最大环境风险因素,同时提出如果我们能够减少空气污染,可能可以挽救数百万人的生命。空气污染到底对我们人类的健康有哪些危害,在这项报告中统计了一下,如果是室外污染,今天空气严重污染的情况,导致的死亡跟我们人类属于心脏病,心梗这一类疾病大约40%左右份额百分比。还有40%的人会根据空气污染的指数发病或者是死亡的事件比较集中,大概占40%左右。所谓脑卒中就是我们说的脑出血这一类疾病。慢阻肺就是常说的慢性支气管炎、肺气肿、肺心病这一类。在导致死亡的原因中,空气污染占很大比例。过去我们可能比较重视室外的空气污染导致的呼吸系统的疾病,但室内空气污染同样应受到重视,34%的脑卒中、22%的慢性阻塞性肺病,能够直接导致跟死亡相关的疾病。
什么是PM2.5?
我们都说空气污染对健康有害,到底空气中哪些有害成分对我们人体造成这样的危害,首先从室外来说,主要是可吸入颗粒,也就是大家现在比较关注的PM2.5,所谓PM2.5指微粒的直径在2.5微米左右,这些污染物吸入到呼吸道导致人类各种疾病问题。室内的空气有哪些有害成分:室内装修材料,主要是甲醛,来源于我们平常空调做饭,取暖这样产生一些物体,苯并芘还有一氧化碳,还有可吸入的微粒氮氧化学物等等。我们中国人煎、炒,一些燃烧不是很完全的燃料像煤、草什么的,燃烧不完全产生氧化氮,造成我们人类一些疾病。另外人类活动也是室内污染的原因之一,如吸烟、飞沫等代谢产物。还有生物性污染,如室内由于清洁强度不够而滋生的细菌、病毒、霉菌,这些对肌体产生损害造成疾病。还有家用电器,家用化学产品如清洁剂等等,里头都会含有易挥发的有机物。这些有害的物质,导致室内污染,有一些是不可避免,或者不太被重视的。潜移默化还是在危害着我们人类健康。
刚才讲室外污染最主要的是可吸入颗粒,也就是PM2.5,PM10等等这些情况,现在明确的研究证实了他们是可以缩短人的寿命,PM2.5被提的比较多,也比较热门,是因为粒子大小决定的。人类呼吸的时候产生一定的气流,PM2.5红颜色的颗粒,会通过我们人的鼻咽没有阻拦直接可以到肺里,所以它的危害是最大的。那么在这个2.5到10这个中小粒子,主要分布到中气道和大气道,这些粒子有的在中气道来回转,被呼出去了,有的占在大中气道里,对人们的健康有一定的危害。
PM值大于10一般所谓的一道防线,口腔的功能阻止了污染物的侵入,随着我们痰都排除了,这个是危害小一点。而PM2.5颗粒就不一样了,由于肺的血液是非常丰富的,有两套供血系统,所以PM2.5和PM2.5以下的微粒可以直接侵入,不经过我们肝脏的首波效应,它直接进入血液循环,直接对我们毛细血管产生损害。PM2.5是我们比较关注的,也是危害比较大的一个微粒。长期暴露在这种颗粒中很容易引发一些敏感肌体或老弱肌体的人,患心血管和呼吸道以及肺癌风险明显增加,另外高污染城市中,死亡率要比相对清洁这个城市死于污染环境引起的死亡要高十五到二十倍,即使比较清洁所谓欧盟的国家里头,由于人类活动产生的PM2.5,同样也是比期望减少8.6个月,这个是比较权威的研究机构公布的数据。
2氮硫化合物对人类危害
二氧化硫对人类活动危害
上面是PM2.5,我们刚才说室外环境影响还有一个物质,就是二氧化硫;主要是影响人类的心和肺的功能,现在研究证实,这个二氧化硫会引起呼吸系统和降低肺功能,比较敏感的人会感觉到眼睛有刺激不舒服。尤其是长期在国外待着,一下飞机就觉得鼻子眼睛都不舒服。对呼吸道刺激以后,产生严重反应,可能就导致咳嗽、痰液增加。有支气管的患者,接触高浓度二氧化硫导致加重,有一部分人,每一次加重是肺功能下降,缩短平均寿命。这样二氧化硫浓度比较高的时候,呼吸道的严格会有一个明显的刺激作用。那么诱发黏膜损伤,可能更容易导致呼吸系统的感染。而且感染以后,如果二氧化硫浓度持续存在的话,刺激咳嗽等等是千年不遇很难治愈。让大暴露在十分钟左右,就检测到呼吸和肺功能一系列的变化。

汽车尾气排除的超标氮、硫化合物(图片来源于百度图片)
如果是呼气二氧化碳的含量,这种活跃到一定的程度就是哮喘发作,就是这个道理。空气中二氧化硫的水平严重超标的日子里,我们在门诊急诊可以看到大量的病人,会诱发心绞痛,不舒服。有的病人可能诱发一次心绞痛什么的。这是二氧化硫。

工业污染造成的大气污染是空气污染的主要病因(图片来源于昵图网)
二氧化氮对人类活动危害
二氧化氮大家可能也都是听说过比较关注,它现在认为,这呼吸道的损伤可能是更为明显的。现在有研究认为,如果短期内超过浓度很高,200微克以上每立方米引起呼吸道一些炎症。认为他浓度很高以后,甚至是一种可以等同有毒的气体,对人的呼吸系统带来损伤,在哮喘当中,如果经常接触或者是短期接触很高的二氧化氮,诱发这个发作。刚才讲的是使用的空气室外空气污染对我们人类健康,主要是心肺系统心脑血管影响。室内空气质量,对我们人类健康是更为建设,我们人的一生80%的时间是室内渡过,除了夜里10几个小时之外,上班除了室外工作,基本上在室内工作,尤其是这些婴幼儿,孕产妇等等。一个是气道和心血管比较脆弱,容易受损伤,所以他们对空气污染更敏感一些群体,室内的空气污染,对呼吸道肯定得影响,心脑血管有影响,神经系统有影响,还有胎儿的发育,生长发育都是有一定影响的。
3吸烟等其他污染物危害
吸烟等其他污染物危害
我们室内污染最常见燃烧物,植物油。是一个很强的致癌物质,还有吸烟的烟雾,产生这种高致癌物质,还有就是高温植物的。
还有就是一氧化碳,一氧化碳中毒导致缺氧。他这种空气中有了大量的一氧化碳污染之后,导致我们人体长期缺氧的状态,影响心血管,缺氧对全身各个系统有影响的。对胎儿的发育有影响。有先天性得疾病。
在一些中小城市主要是取暖和做饭,烹调主要的能源,还有燃油。还有就是燃气污染,不完全燃烧的废气,还有在农村或者一些地区烧的柴草,木头。桔梗,麦秸。生物原料产生大量的一氧化碳,对呼吸系统有很严重的影响。

92年开始就已经环境保护已经认定为A级致癌物质(图片来源于百度图片)
还有就是烟草,92年开始就已经环境保护已经认定为A级致癌物质,而且都是不安全的。少量的不安全,同时是二手烟三手烟,公共场所的环境都是有很大的影室内化学污染,主要是装修材料来源一些东西,可以导致败血病,尤其是儿童的,还有心脏病的发作,各种肿瘤,贫血、尿毒症等等。
现在最主要是甲醛,一种有机挥发的气体,我们装卸除了要选好材料以外,适当要清甲醛,通风。吸甲醛的东西做相应的处理。还有一些氮等等,有些是我们室内化学污染起到一些来源,主要在装修这一块。
其次就是室内一个微生物的影响,微生物尘霾大家都清楚。现在养狗比较多,还有分泌物、尿液,其中都含有这些成分,如果是敏感的肌体,会导致感染和一系列的过敏反应,尤其是有哮喘有鼻咽,像这个季节就比较多。还有一些生物的像鸽子,经常会有一些病人找不着原因,发烧喘,详细问邻居家楼上养一群鸽子,他们的粪便、羽毛飘下来,闻到颗粒以后就喘。
上面列举了种种我们常见的大气的也好,室内的也好,污染是很严重,北京现在情况也很清楚。属于比较重度污染一个城市,我们能干什么?我们能做一些什么,首先从自我做起,保证一个绿色的出行,少开车,然后能步行的步行,自行车其实挺不错一个交通工具,搭乘公交车地铁,还有拼车的。污染严重,空气比较严重的时候雾霾天不要快窗,如果一定有户外的活动,上班这个口罩比较重要了。
在室内一些污染,一个是在室内不吸烟,二选择比较靠谱质量过关一些空气的净化器,也是一个选择。另外外界比较污染的时候,少通风换气,注意室内环保的产品。
截止到2012年空气污染造成非正常死亡人数,过早的死亡,跟空气污染有关系的这种非正常死亡达到了700万人。据较保守的调查,每八位死者中有一位死于跟空气污染有关。
毛俊霆

推荐经销商